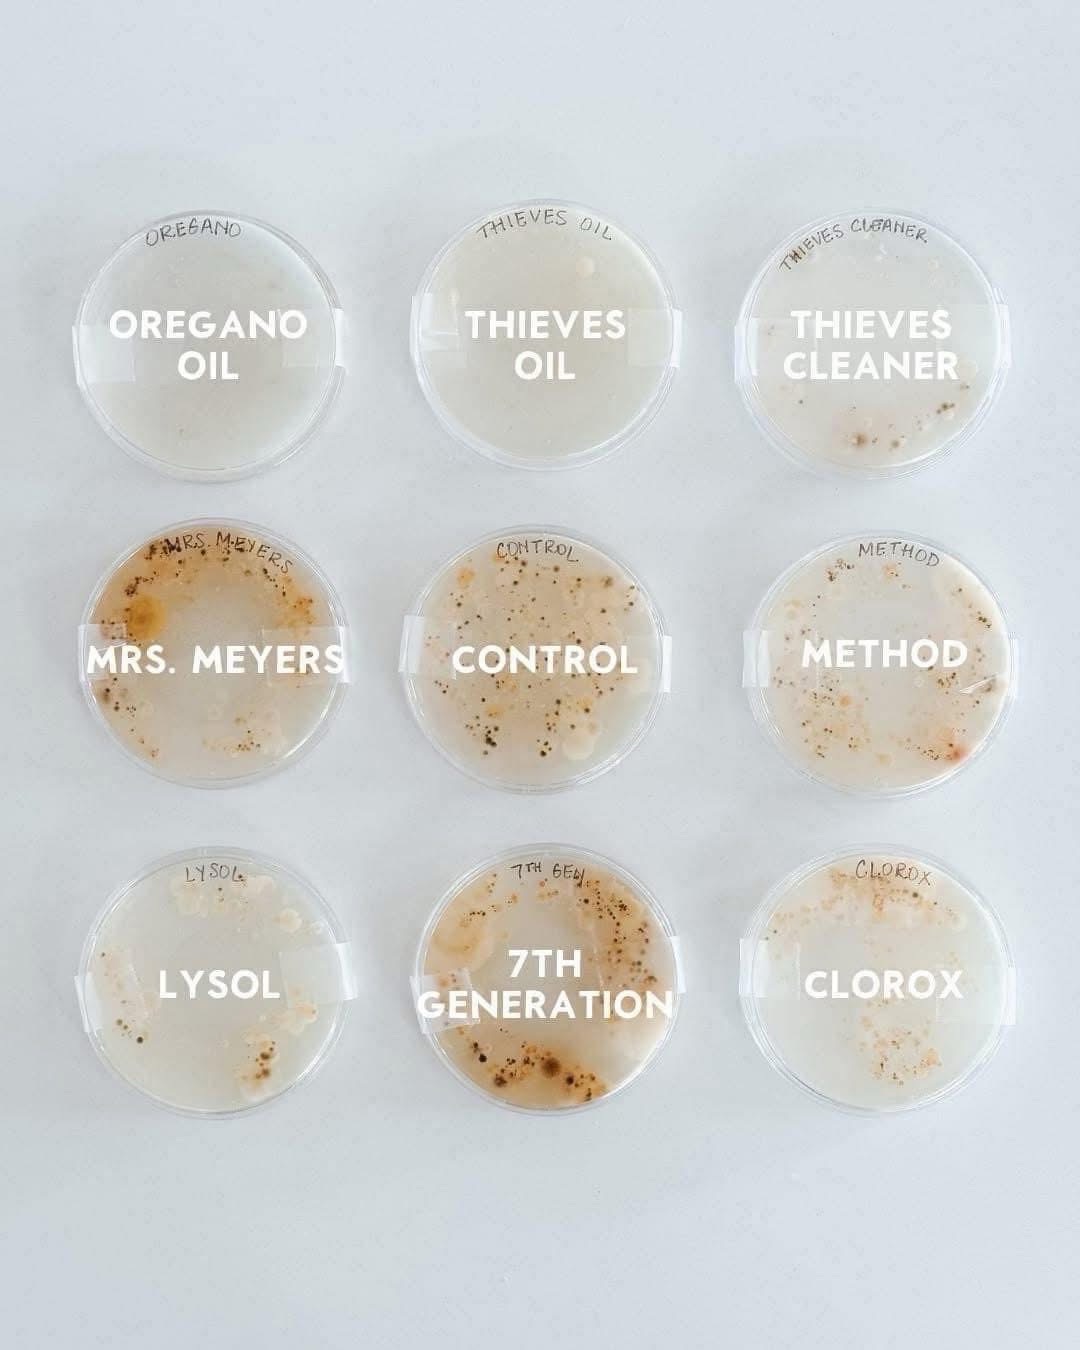

We made the switch to Thieves products ten years ago and it has been one of the best changes we have made for our family.
Thieves products are plant based, all natural and potent! A picture is worth a thousand words. Just look at the image below to see how Thieves responds to bacteria vs its chemical laden counterparts. And of course Thieves oil is a key ingredient in Thieves Cleaner so it smells amazing!
Teacher friends, my students with asthma and respiratory issues comment that they can actually breathe in my room. And everyone comments on how good my room smells. No one likes hearing this but: Ditch those Clorox wipes and Lysol! ![]()
If you have been looking to make the switch but hesitant due to cost, you actually may want to consider Thieves Household Cleaner.
It’s a concentrate so you just use two capfuls in an empty spray bottle and fill the rest of the way with water. This costs pennies and it’s so easy!
The bottle of concentrate that I currently have has lasted more than 6 months and it’s still not empty. I make a bottle for the bathroom, kitchen and one for my classroom.
Added benefits include: not breathing in harmful chemicals, no sneezing, nose burning or throat closing as a consequence of this.
The quality of the air you breathe, and that your family breathes matters. This is especially true if anyone in your household has severe allergies, asthma or other respiratory issues.
Screenshot/pm me your order of Thieves Cleaner today and I will gift you with my very favorite spray bottle!
Link to Thieves products (game changer!) https://tinyurl.com/36fay7s8